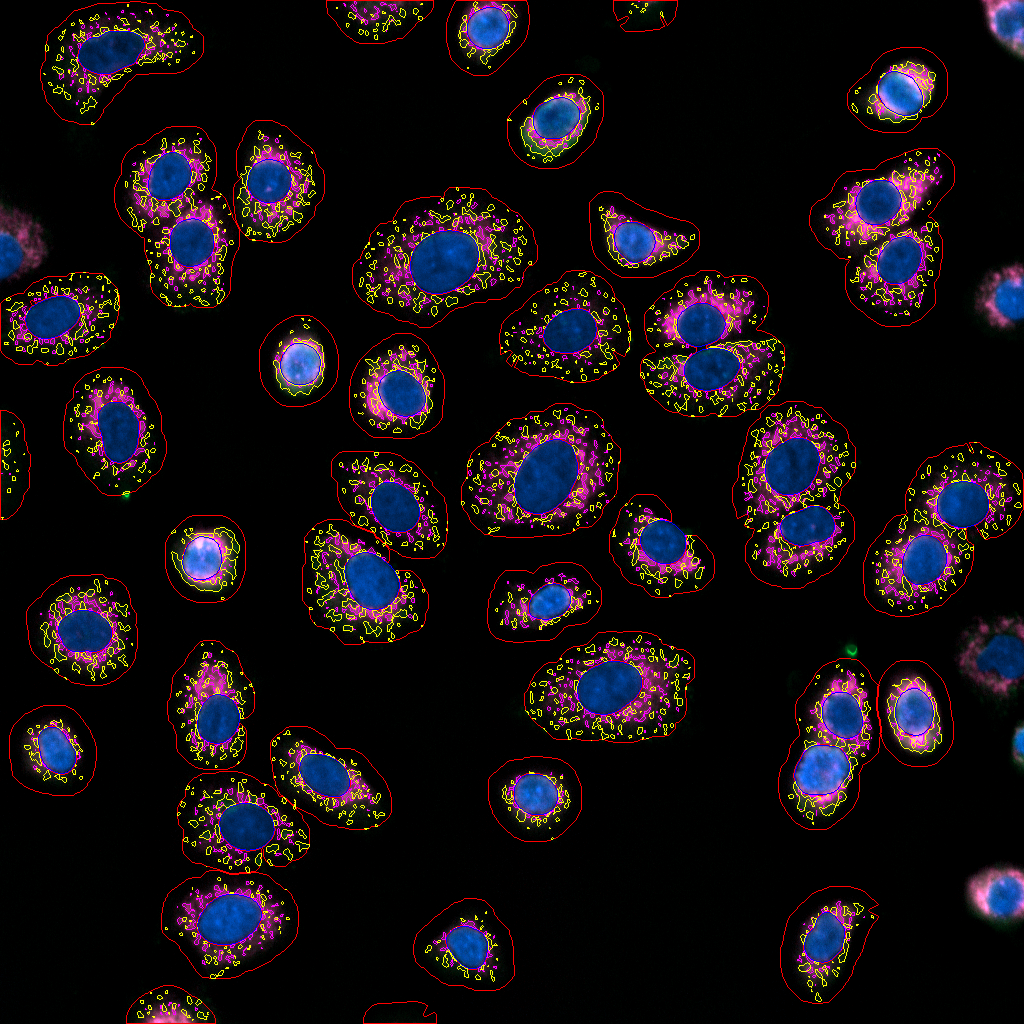
1R.bmp

Targeting Mitochondria for Tomorrow's Health
CELL IMAGING
At Mitopharma, six automated imaging systems support advanced cellular and in vivo analysis. These include two live-cell high-content screening systems, a high-resolution time-lapse TIRF imaging system, a spectral true confocal scanning microscopy system, an intravital spectral confocal scanning microscopy system and an imaging flow cytometry system. Long-term time-lapse mitochondrial dynamics data are analyzed using machine learning algorithms on a high performance computing server.
Anything that can be labeled can be imaged. From real-time tracking of cell receptor activation and translocation to the quantification of transcription factor expression and localization within cells. Cellular events are visualized using developed stable reporter cell lines, probes and immunocytochemistry.
Mitochondrial dynamics, cytoskeleton dynamics, cell-cell communication and other challenging high-resolution demanding imaging is performed using confocal and TIRF microscopy. Cells are also imaged and analyzed over long time-lapse experiments using label-free live-cell phase contrast microscopy system.